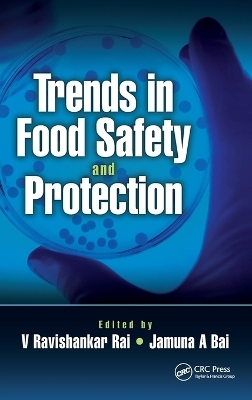
Trends in Food Safety and Protection

Buch | Hardcover
2017
|
Routledge
ISBN: 9780415820509
CHF 249,95 (inkl. MwSt)
- Versand in
10-15 Tagen